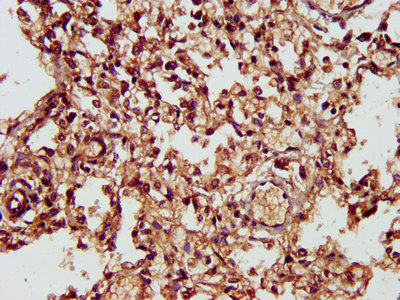

CHST11 Antibody
-
中文名稱:CHST11兔多克隆抗體
-
貨號:CSB-PA882066LA01HU
-
規格:¥440
-
圖片:
-
IHC image of CSB-PA882066LA01HU diluted at 1:300 and staining in paraffin-embedded human lung tissue performed on a Leica BondTM system. After dewaxing and hydration, antigen retrieval was mediated by high pressure in a citrate buffer (pH 6.0). Section was blocked with 10% normal goat serum 30min at RT. Then primary antibody (1% BSA) was incubated at 4°C overnight. The primary is detected by a biotinylated secondary antibody and visualized using an HRP conjugated SP system.
-
IHC image of CSB-PA882066LA01HU diluted at 1:300 and staining in paraffin-embedded human liver cancer performed on a Leica BondTM system. After dewaxing and hydration, antigen retrieval was mediated by high pressure in a citrate buffer (pH 6.0). Section was blocked with 10% normal goat serum 30min at RT. Then primary antibody (1% BSA) was incubated at 4°C overnight. The primary is detected by a biotinylated secondary antibody and visualized using an HRP conjugated SP system.
-
-
其他:
產品詳情
-
產品名稱:Rabbit anti-Homo sapiens (Human) CHST11 Polyclonal antibody
-
Uniprot No.:
-
基因名:CHST11
-
別名:C4S-1 antibody; C4ST 1 antibody; C4ST antibody; C4ST-1 antibody; C4ST1 antibody; Carbohydrate (chondroitin 4) sulfotransferase 11 antibody; Carbohydrate sulfotransferase 11 antibody; Chondroitin 4 O sulfotransferase 1 antibody; Chondroitin 4 sulfotransferase antibody; Chondroitin 4-O-sulfotransferase 1 antibody; Chondroitin 4-sulfotransferase 1 antibody; CHST 11 antibody; Chst11 antibody; CHSTB_HUMAN antibody; HSA269537 antibody; IgH/CHST11 fusion antibody
-
宿主:Rabbit
-
反應種屬:Human
-
免疫原:Recombinant Human Carbohydrate sulfotransferase 11 protein (214-330AA)
-
免疫原種屬:Homo sapiens (Human)
-
標記方式:Non-conjugated
本頁面中的產品,CHST11 Antibody (CSB-PA882066LA01HU),的標記方式是Non-conjugated。對于CHST11 Antibody,我們還提供其他標記。見下表:
-
克隆類型:Polyclonal
-
抗體亞型:IgG
-
純化方式:>95%, Protein G purified
-
濃度:It differs from different batches. Please contact us to confirm it.
-
保存緩沖液:Preservative: 0.03% Proclin 300
Constituents: 50% Glycerol, 0.01M PBS, pH 7.4 -
產品提供形式:Liquid
-
應用范圍:ELISA, IHC
-
推薦稀釋比:
Application Recommended Dilution IHC 1:200-1:500 -
Protocols:
-
儲存條件:Upon receipt, store at -20°C or -80°C. Avoid repeated freeze.
-
貨期:Basically, we can dispatch the products out in 1-3 working days after receiving your orders. Delivery time maybe differs from different purchasing way or location, please kindly consult your local distributors for specific delivery time.
-
用途:For Research Use Only. Not for use in diagnostic or therapeutic procedures.
相關產品
靶點詳情
-
功能:Catalyzes the transfer of sulfate to position 4 of the N-acetylgalactosamine (GalNAc) residue of chondroitin. Chondroitin sulfate constitutes the predominant proteoglycan present in cartilage and is distributed on the surfaces of many cells and extracellular matrices. Can also sulfate Gal residues in desulfated dermatan sulfate. Preferentially sulfates in GlcA->GalNAc unit than in IdoA->GalNAc unit. Does not form 4, 6-di-O-sulfated GalNAc when chondroitin sulfate C is used as an acceptor.
-
基因功能參考文獻:
- A C4ST-1 construct was designed and expressed in both Escherichia coli and Pichia pastoris in its non-glycosylated and glycosylated forms. Both constructs showed similar activity albeit different kinetic parameters when acting on a microbially prepared unsulfated chondroitin substrate. Moreover, the glycosylated form of C4ST-1 showed lower stability than the non-glycosylated form. PMID: 28761999
- data demonstrate that the hip osteoarthritis susceptibility is mediated by differential protein binding to the alleles of rs835487 and rs835488, which are located within an enhancer whose target may be CHST11 during chondrogenesis or an alternative gene. PMID: 27391021
- These results have demonstrated that CHST11 and CHST13 negatively modulate metastasis and drug resistance of HCC cells probably via oncogenic MAPK signal pathway. PMID: 26993826
- We conclude that CHSTs involved in the synthesis of CS-A and CS-E might influence ovarian cancer progression, and we suggest CHST11 as independent unfavorable prognostic factor in this entity. PMID: 26084610
- CHST11 may play a direct role in progression of breast cancer and that its expression is controlled by DNA methylation. Therefore, in addition to CHST11 mRNA levels, the methylation status of this gene also has potential as a prognostic biomarker. PMID: 25586191
- Silencing Wnt9A increased the expression of CHST11 in the colonic epithelial cells, and chromatin immunoprecipitation assay demonstrated enhancing effects of Wnt9A siRNA and exogenous BMP4 on the CHST11 promoter PMID: 25511584
- reduced C4ST-1 expression and chondroitin sulfation imbalance mediating the effects of oncogenic HRAS signaling in the pathogenesis of Costello syndrome. PMID: 22317973
- Cell surface P-selectin binding depends on CHST11 gene expression. CSPG4 serves as a P-selectin ligand through its CS chain and participates in P-selectin binding to the highly metastatic breast cancer cells. PMID: 21658254
- Forced expression of C4ST-1 in L-Wnt-3a cells inhibited diffusion of Wnt-3a due to structural alterations in CS chains mediated by C4ST-1. PMID: 21123170
- identified TGFbeta- responsive regulatory modules that can function in a cell type-specific fashion. Taken together, our results identify TGFbeta-dependent and -independent cis-regulatory modules of the C4ST-1 gene PMID: 19937589
- human D4ST-1, C4ST-1, and S4ST-2 have differential roles in dermatan sulfate biosynthesis PMID: 12847091
- C4ST-1 and C6ST-1 differ from each other in the recognition of uronic acid residues adjacent to the targeted GalNAc residue PMID: 15324304
顯示更多
收起更多
-
相關疾病:A chromosomal aberration involving CHST11 is found in B-cell chronic lymphocytic leukemias. Translocation t(12;14)(q23;q32) with IgH.
-
亞細胞定位:Golgi apparatus membrane; Single-pass type II membrane protein.
-
蛋白家族:Sulfotransferase 2 family
-
組織特異性:Widely expressed. Highly expressed in spleen, thymus, bone marrow, peripheral blood leukocytes, lymph node, heart, brain, lung and placenta.
-
數據庫鏈接:
Most popular with customers
-
-
YWHAB Recombinant Monoclonal Antibody
Applications: ELISA, WB, IHC, IF, FC
Species Reactivity: Human, Mouse, Rat
-
Phospho-YAP1 (S127) Recombinant Monoclonal Antibody
Applications: ELISA, WB, IHC
Species Reactivity: Human
-
-
-
-
-